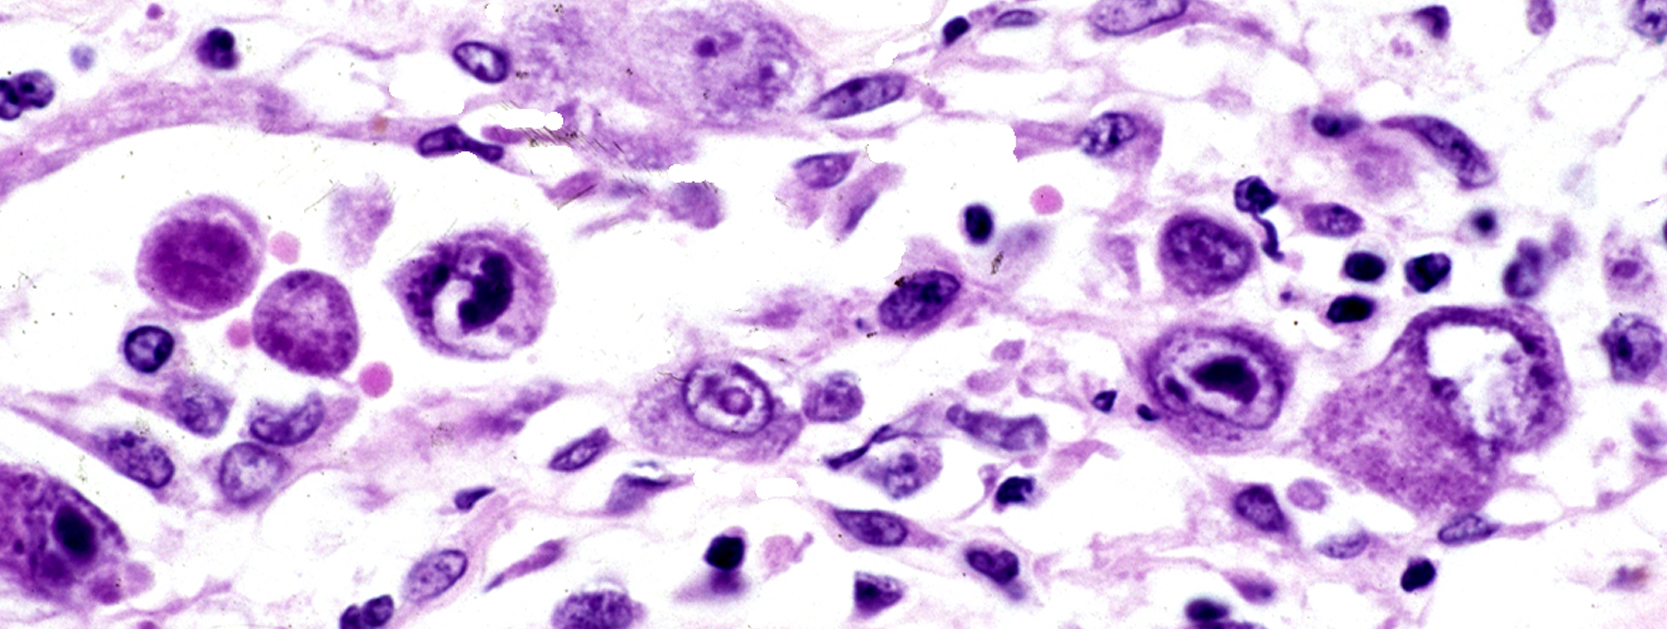

We are AW Dermatopathology
AW DermPath’s reputation for accurate and timely reporting has made us one of the foremost dermatopathology laboratories in the Gulf South. With our experienced staff and commitment to customer relationships, we are able to support our referring physicians by providing rapid pick-up and accurate evaluation and reporting for all specimens. By working together with our referring physicians, we are able to provide the best possible care for every patient.